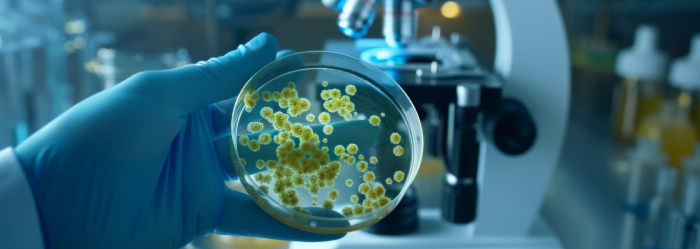
Microbiology Department

kurmasanskritimedical@gmail.com +91-9155266001, 9955990975
The Department of Microbiology at Kurma Sanskriti Medical College & Hospital deals with the study of microorganisms including bacteria, viruses, fungi, and parasites that are responsible for human diseases.
The department plays a vital role in infection diagnosis, prevention, and control by providing laboratory support for clinical services while imparting strong practical and theoretical knowledge to medical students.